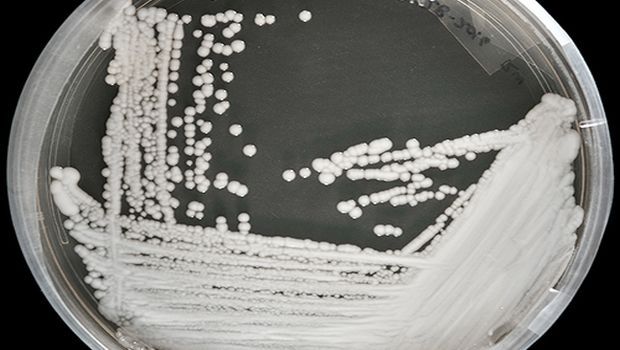
Pilzinfektionen breiten sich in den USA mit "alarmierender" Geschwindigkeit aus

Pilzinfektionen breiten sich in den USA mit "alarmierender" Geschwindigkeit aus
Aus diesem Grund hat die CDC es als "dringende Bedrohung durch antimikrobielle Resistenz" bezeichnet. Viele Patienten befinden sich in Krankenhäusern und Altenpflegeheimen.Einer von drei Patienten mit invasiven Infektionen stirbt, aber es kann schwierig sein, die genaue Rolle einzuschätzen, die Candida auris bei gefährdeten Patienten spielt, sagte CDC-Epidemiologin Dr. Meghan Lyman, die Hauptautorin des Berichts.
Die Infektion wurde erstmals 2016 in den USA gemeldet. Der schnellste Anstieg der Fälle war von 2020 bis 2021, laut CDC-Daten, die in den Annals of Internal Medicine veröffentlicht wurden.
Ein weiterer Grund zur Besorgnis war die Zunahme von Fällen, die "resistent gegen Echinocandine" wurden, das am häufigsten zur Behandlung der Infektion empfohlene Antimykotikum.Die CDC führt den Anstieg auf eine schlechte Infektionsprävention in Gesundheitseinrichtungen und verstärkte Screening-Bemühungen zurück.
Es könnte sich auch aufgrund der Belastung des Gesundheitswesens und der öffentlichen Gesundheitssysteme während der Covid-19-Pandemie verschlechtert haben.
Dr. Lyman sagte gegenüber CBS News, der Anstieg "betont die Notwendigkeit einer kontinuierlichen Überwachung, erweiterter Laborkapazität, schnellerer diagnostischer Tests und der Einhaltung bewährter Infektionsprävention und -kontrolle".
Auch andere Länder verzeichnen einen Anstieg der Fälle von Candida auris. Im vergangenen Jahr hat die Weltgesundheitsorganisation ihn in ihre Liste der "prioritären Pilzerreger" aufgenommen.
Agenturen/bnm






